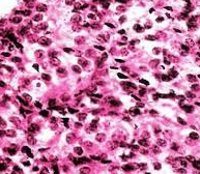

Другие названия и синонимы
Granular cell carcinoma of the kidney, Гранулярно-клеточный рак почки.
МКБ-10 коды
|
|
Описание
Зернисто. Клеточная карцинома почки - гистологическая форма почечно - клеточного рака, развивающегося из паренхимы органа. Проявляется ренальными (гематурией, болью, пальпируемой опухолью) и экстраренальными (лихорадкой, слабостью, похуданием и тд ) симптомами. Диагноз зернисто-клеточной карциномы устанавливается на основе УЗИ почек, экскреторной урографии, ангиографии, МРТ, КТ, радиоизотопной сцинтиграфии. Лечение включает частичную или радикальную нефрэктомию, нередко - адреналэктомию, иммунотерапию; реже - гормонотерапию, химиотерапию или лучевую терапию.
Дополнительные факты
Зернисто-клеточная карцинома почки (гранулярно-клеточный рак) в урологии встречается в 7-12% от всех случаев почечно-клеточного рака. Макроскопически зернисто-клеточные карциномы имеют коричневатый цвет, обусловленный скоплением фосфолипидных комплексов в многочисленных митохондриях, заполняющих раковые клетки. При микроскопическом исследовании зернисто-клеточная карцинома представлена полигональными клетками с широкой зернистой цитоплазмой, различной степенью клеточной атипии и полиморфизма, обширными зонами кровоизлияний и некроза. Отличительной чертой зернисто-клеточной карциномы является склонность к инвазии опухолью почечной вены.
Причины
Судить о причинах зернисто-клеточной формы рака почки не представляется возможным. В настоящее время выделены прогностические факторы потенциального риска, повышающие вероятность развития рака почки в целом. Замечено, что пик заболеваемости отмечается в возрасте 50-70 лет, причем рак почки 2-3 раза чаще встречается у мужчин. Риск развития рака почки выше у представителей негроидной расы.
Главным предрасполагающим фактором считается курение, повышающее вероятность возникновения рака почки в 2 раза. В числе других вероятных причин выделяют генетическую предрасположенность, некоторые наследственные заболевания, иммунодефицит, ожирение, воздействие ионизирующего излучения, нахождение пациента на длительном гемодиализе.
Главным предрасполагающим фактором считается курение, повышающее вероятность возникновения рака почки в 2 раза. В числе других вероятных причин выделяют генетическую предрасположенность, некоторые наследственные заболевания, иммунодефицит, ожирение, воздействие ионизирующего излучения, нахождение пациента на длительном гемодиализе.
Клиническая картина
Клиническая картина карциномы почки складывается из ренальных и экстраренальных проявлений. К ренальным симптомам относится классическая триада - наличие пальпируемой опухоли, гематурии и боли. Обычно присутствуют 1 или 2 симптома триады, но все они, как правило, уже свидетельствуют о распространенном опухолевом процессе.
Гематурия при зернисто-клеточной карциноме почки наблюдается в 50-60% случаев. При раке почки гематурия интенсивная, развивается внезапно и часто не сопровождается болевым синдромом. Острый болевой приступ может развиться после прекращения гематурии, при обтурации мочеточника кровяным сгустком. При неопухолевых поражения почек, протекающих с гематурией (гидронефрозе, мочекаменной болезни), боль, как правило, предшествует появлению крови в моче. В случае рака почки гематурия носит перемежающийся характер, при этом интервалы между кровотечениями постепенно укорачиваются. Боли в поясничной области встречаются почти у половины пациентов; пальпируемая опухоль - у 30-40%.
Экстраренальная (внепочечная) симптоматика обычно включает беспричинную лихорадку, ухудшение самочувствия, потерю аппетита, слабость, анемию, похудание. У 5-10% пациентов с бластоматозным процессом в почках развивается артериальная гипертензия. У мужчин важным симптомом карциномы почки служит развитие варикоцеле, которое может быть обусловлено сдавлением или опухолевой инвазией почечной вены, одной из яичковых вен либо тромбозом нижней полой вены.
Ассоциированные симптомы: Гематурия. Изменение аппетита. Изменение веса. Истощение. Кровохарканье. Лейкоцитурия. Ломота в мышцах. Лихорадка. Отсутствие аппетита. Потеря веса. Протеинурия.
Гематурия при зернисто-клеточной карциноме почки наблюдается в 50-60% случаев. При раке почки гематурия интенсивная, развивается внезапно и часто не сопровождается болевым синдромом. Острый болевой приступ может развиться после прекращения гематурии, при обтурации мочеточника кровяным сгустком. При неопухолевых поражения почек, протекающих с гематурией (гидронефрозе, мочекаменной болезни), боль, как правило, предшествует появлению крови в моче. В случае рака почки гематурия носит перемежающийся характер, при этом интервалы между кровотечениями постепенно укорачиваются. Боли в поясничной области встречаются почти у половины пациентов; пальпируемая опухоль - у 30-40%.
Экстраренальная (внепочечная) симптоматика обычно включает беспричинную лихорадку, ухудшение самочувствия, потерю аппетита, слабость, анемию, похудание. У 5-10% пациентов с бластоматозным процессом в почках развивается артериальная гипертензия. У мужчин важным симптомом карциномы почки служит развитие варикоцеле, которое может быть обусловлено сдавлением или опухолевой инвазией почечной вены, одной из яичковых вен либо тромбозом нижней полой вены.
Ассоциированные симптомы: Гематурия. Изменение аппетита. Изменение веса. Истощение. Кровохарканье. Лейкоцитурия. Ломота в мышцах. Лихорадка. Отсутствие аппетита. Потеря веса. Протеинурия.
Диагностика
Визуально и пальпаторно могут быть обнаружены только запущенные формы рака почек. При осмотре уролог или нефролог может обратить внимание на варикоцеле, отеки на нижних конечностей, расширение подкожных вен на передней брюшной стенке. Пальпация опухоли и степень ее подвижности позволяют судить о распространенности ракового процесса.
Из тестов лабораторной диагностики при обследовании используются общий анализ мочи (эритроцитурия, лейкоцитурия, протеинурия) и общий анализ крови (анемия, повышение СОЭ), биохимические исследования крови, однако все обнаруживаемые в них изменения являются неспецифичными. Патогномоничным признаком почечной карциномы служат изменения метаболизма сывороточных белков (трансферрина, ферритина, альбумина), выявляемые с помощью иммунодиффузного анализа.
Важным этапом онкоурологического обследования является УЗИ почек, посредством которого удается выявить деформацию контуров паренхимы, прорастание опухоли в сосуды, тромбоз вен, увеличенные регионарные лимфоузлы Ультрасонография помогает дифференцировать карциному от гидронефроза, пионефроза, поликистоза почек, солитарной кисты почки.
Рентгенологическое обследование начинают с выполнения обзорной урографии, позволяющей судить об изменении конфигурации почки. В дальнейшем проводится экскреторная урография, дающая сведения о морфологическом и функциональном состоянии пораженной и здоровой почки. Для оценки заинтересованности почечных сосудов и степени васкуляризации опухоли прибегают к выполнению УЗДГ и почечной ангиографии. В случае подозрения на опухолевый тромб - нижней кавографии и почечной венографии.
С целью стадирования бластоматозного процесса используется магнитнорезонансная, компьютерная томография, нефросцинтиграфия. Биопсия почки ввиду опасности рассеивания опухоли применяется редко. С целью выявления отдаленного метастазирования показано проведение рентгенографии легких и костей, УЗИ органов брюшной полости.
Из тестов лабораторной диагностики при обследовании используются общий анализ мочи (эритроцитурия, лейкоцитурия, протеинурия) и общий анализ крови (анемия, повышение СОЭ), биохимические исследования крови, однако все обнаруживаемые в них изменения являются неспецифичными. Патогномоничным признаком почечной карциномы служат изменения метаболизма сывороточных белков (трансферрина, ферритина, альбумина), выявляемые с помощью иммунодиффузного анализа.
Важным этапом онкоурологического обследования является УЗИ почек, посредством которого удается выявить деформацию контуров паренхимы, прорастание опухоли в сосуды, тромбоз вен, увеличенные регионарные лимфоузлы Ультрасонография помогает дифференцировать карциному от гидронефроза, пионефроза, поликистоза почек, солитарной кисты почки.
Рентгенологическое обследование начинают с выполнения обзорной урографии, позволяющей судить об изменении конфигурации почки. В дальнейшем проводится экскреторная урография, дающая сведения о морфологическом и функциональном состоянии пораженной и здоровой почки. Для оценки заинтересованности почечных сосудов и степени васкуляризации опухоли прибегают к выполнению УЗДГ и почечной ангиографии. В случае подозрения на опухолевый тромб - нижней кавографии и почечной венографии.
С целью стадирования бластоматозного процесса используется магнитнорезонансная, компьютерная томография, нефросцинтиграфия. Биопсия почки ввиду опасности рассеивания опухоли применяется редко. С целью выявления отдаленного метастазирования показано проведение рентгенографии легких и костей, УЗИ органов брюшной полости.
Лечение
При выявлении операбельной карциномы почки показана хирургическая тактика. Операция на почке проводится даже в случае обнаружения одиночного метастаза, поскольку позволяет продлить жизнь больному. При ранней диагностике карциномы возможно выполнение частичной нефрэктомии, однако чаще производится тотальная нефрэктомия, нередко с односторонней адреналэктомией и удалением регионарных лимфоузлов, извлечением опухолевых тромбов из почечной и нижней полой вен.
К назначению лучевой терапии, химиотерапии или гормонотерапии прибегают при неоперабельности почечного рака. Лучший прогностический результат достигается проведением иммунотерапии альфа-интерфероном, 5-фторурацилом, интерлейкином-2, которая позволяет повысить сроки выживаемости.
К назначению лучевой терапии, химиотерапии или гормонотерапии прибегают при неоперабельности почечного рака. Лучший прогностический результат достигается проведением иммунотерапии альфа-интерфероном, 5-фторурацилом, интерлейкином-2, которая позволяет повысить сроки выживаемости.
Прогноз
Отдаленный прогноз во многом определяется стадией бластоматозного поражения. Течение зернисто-клеточной карциномы почки в большинстве случаев неблагоприятное; прогноз ухудшается при прорастании опухоли в почечную вену, наличии отдаленного метастазирования. Профилактика рака почек требует отказа от курения, исключения неблагоприятных химических и ионизирующих воздействий на организм.
|
|